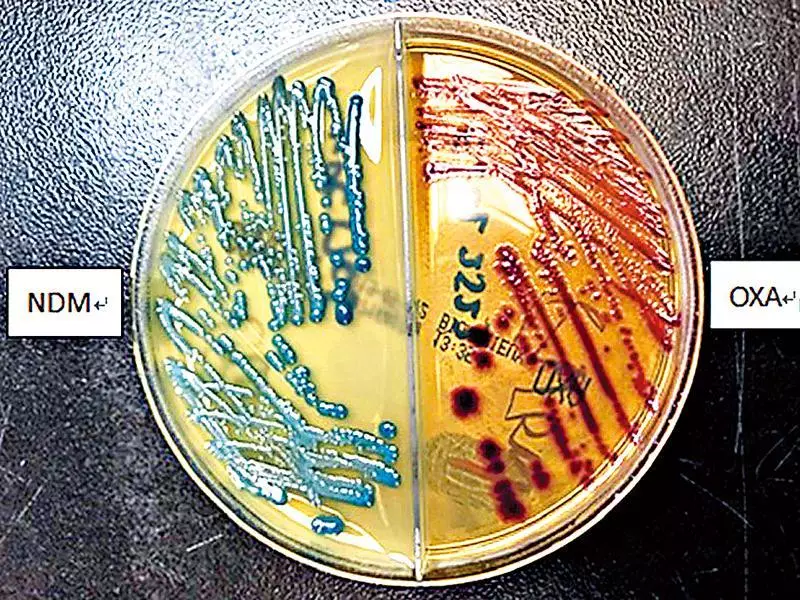

衞生防護中心正調查一宗抗藥惡菌「產碳青黴烯酶腸道桿菌」(CPE)帶菌個案羣組,涉及黃大仙區一間護老院的6名院友。中心不排除該院舍早前出現未被發現的帶菌者,透過被污染的環境或共用物品導致院內傳播,並提醒院舍按照「安老院預防傳染病指引」執行預防和控制措施。
產碳青霉烯酶腸道桿菌(CPE)。網上圖片
兩名院友入院篩查揭發
中心早前接獲醫院管理局通知,指該院舍同一樓層有兩名院友,因自身疾病近期先後入住公立醫院。他們的入院篩查樣本經化驗後,證實帶有產碳青黴烯酶腸道桿菌。中心其後展開流行病學調查及接觸者篩查,發現另外4宗帶菌個案。
六名帶菌者情況穩定
該6名院友年齡介乎67至95歲,均屬帶菌者,沒有出現產碳青黴烯酶腸道桿菌感染的相關病徵,情況穩定。
已巡查院舍並提供建議
中心人員已巡查涉事院舍,提醒院舍必須按指引妥善進行護理程序、徹底清潔及消毒環境,確保員工和院友手部衞生。中心亦建議院舍將帶菌者集中安置在同一區域,並確保提供足夠的潔手設施。
中心會繼續調查個案羣組,在院舍為接觸者進行另一輪篩查,以確定是否有其他帶菌者,也會繼續對該院舍進行醫學監察。

衞生防護中心。資料圖片









